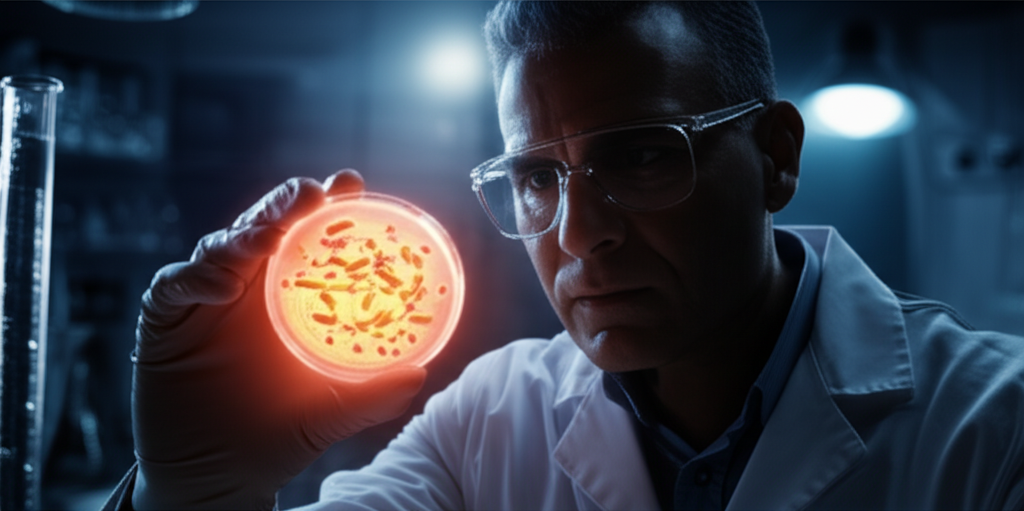
Novo Antibiótico Revoluciona a Luta Contra Superbactérias

O que nos ensinou a descoberta do Nanotyrannus?
O Nanotyrannus não é apenas mais um fóssil intrigante; é uma janela para compreendermos melhor o ecossistema de predadores que povoou a América do Norte no final do Cretáceo. Imagine a cena: gigantes como o T. rex dominando a paisagem, enquanto criaturas menores e mais ágeis, como o Nanotyrannus, coexistiam, caçando presas menores. A resistência a aceitar o Nanotyrannus como uma espécie independente revela muito sobre a ciência: ela é um campo em constante evolução, com suas teorias continuamente revisadas.
Em 1942, quando o primeiro crânio do Nanotyrannus lancensis foi encontrado, a ideia de que poderia não ser um juvenil do T. rex estava à procura de validação. A confusão se intensificou com a descoberta de outros fósseis, especialmente o esqueleto conhecido como “Jane”. Se pensarmos em termos de história, é como se estivéssemos à frente de um enredo que se desenrolava lentamente, misturando suspense e revelações a cada nova pista no caminho.
Como a ciência desvendou essa trama?
Após a redescoberta do fóssil de Montana — parte do famoso achado dos “Dinossauros em Duelo” —, os cientistas liderados por Lindsay Zanno e James Napoli realizaram uma análise meticulosa, comparando o esqueleto com mais de 200 outros fósseis. O resultado? O esqueleto pertencia a um adulto de aproximadamente 20 anos, pesando cerca de 700 quilos e medindo cerca de seis metros. Essa conclusão paradigma é vital. Se pensarmos nos dinossauros como uma grande orquestra, o T. rex seria o enorme trompete, enquanto o Nanotyrannus seria um violino ágil, tocando uma melodia diferente e igualmente poderosa.
Os cientistas perceberam que o Nanotyrannus possuía características distintas do T. rex: braços mais longos, um número maior de dentes e padrões cranianos únicos. É como reconhecer que, em uma família de artistas, mesmo os que tocam instrumentos distintos podem brilhar de maneiras diferentes. Essa descoberta não apenas redefine a identidade do Nanotyrannus, mas também abre portas para a reavaliação de inúmeros estudos que se basearam em fósseis errôneos.
O que isso significa para a paleontologia?
Considerar o Nanotyrannus como uma espécie à parte é mais que uma simples etiqueta. É um chamado para uma revisão das conclusões sobre o comportamento e o crescimento do T. rex. Afinal, como a ciência molda nosso entendimento do passado, os novos dados nos mostram que precisamos reexaminar o que sabemos. Imagine que, durante anos, achamos que um livro estava escrito de uma determinada maneira e agora recebemos um novo capítulo, adicionando profundidade e complexidade à narrativa.
Uma questão intrigante permanece: como eram os adolescentes do T. rex? Agora, ao olharmos para os fósseis do Nanotyrannus, temos mais perguntas do que respostas. É o típico enigma que alimenta a curiosidade humana, convidando-nos a explorar mais a fundo.
E qual é a implicação para nós?
Mas o que isso realmente significa na prática para o nosso dia a dia? Essa revisão tem um impacto mais amplo do que se imagina. Quando debates científicos se tornam amplamente reconhecidos, influenciam nossa compreensão do comportamento animal moderno, já que as lições sobre adaptação e coexistência ressoam até mesmo em nossas interações sociais. Criaturas menores tentando conquistar seu espaço em um mundo dominado por gigantes é uma narrativa comum em qualquer sociedade.
O Nanotyrannus nos lembra que a diversidade é chave, tanto na natureza quanto entre nós. Assim, ao refletirmos sobre a coexistência de diferentes espécies de tiranossauros, podemos também pensar em como promovemos a diversidade nas comunidades atuais, seja em nossa vizinhança ou no ambiente de trabalho.
O Futuro da Investigação: Para onde vamos agora?
Após essa descoberta, as perguntas não cessam. Como será que o Nanotyrannus interagia com seu principal concorrente, o T. rex? Haverá outros fósseis esperando para serem desenterrados, trazendo mais respostas rapidamente? O debate sobre o que caracteriza uma espécie vai continuar a desafiar paleontólogos. Scott Williams, um especialista no tema, prevê que essa discussão não terminará tão cedo. É importante continuarmos a acompanhar as novas descobertas que podem surpreender até os mais céticos.
A revelação de que o Nanotyrannus era uma espécie distinta é um lembrete poderoso de que o conhecimento está sempre em desenvolvimento. Cada nova descoberta ilumina mais sobre os dinossauros do passado e, ao mesmo tempo, nos envolve em um diálogo fascinante sobre a vida e a ciência.
Em suma, a história do Nanotyrannus é mais do que a simples identificação de uma nova espécie. É um convite à reflexão sobre o papel da ciência e da curiosidade humana, algo que todos nós podemos abraçar. Afinal, quem não quer estar a par dos encantos e mistérios que a história natural nos oferece?
A fonte principal para esta discussão é o site da Super. Além disso, para quem deseja explorar mais, a pesquisa completa está disponível na revista Nature.
Se você ficou curioso, continue explorando. Descubra mais em Chutar o Balde. O universo do conhecimento nunca é pequeno demais para quem se atreve a perguntar.